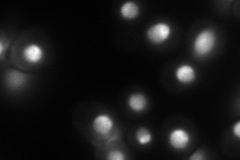
YPR143W
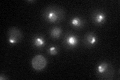
YPR143W

View description
Nucleolar protein, constituent of pre-60S ribosomal particles; required for proper processing of the 27S pre-rRNA at the A3 and B1 sites to yield mature 5.8S and 25S rRNAs
Localization:
Intensity:
Fold change:
Significance:
-
C’ GFP library in SD

nucleus77.76 -
N' NOP1pr-GFP in SD
nucleus,nucleolus134.602 -
N' TEF2pr-mCherry in SD

vacuole0 -
N' NATIVEpr-GFP in SD

nucleus,nucleolus57.3922 -
N' TEF2pr-VC and Cyto-VN in SD

nucleus,nucleolus52.6357 -
C’ GFP library in SD+DTT

nucleus59.350.76No -
C’ GFP library in SD+H2O2

nucleus60.210.77No -
C’ GFP library in Starvation Media
punctateN/AN/AYes -
C’ GFP library on the background of Pup2-DaMP

nucleus -
C’ GFP library on the background of CCT mutant

nucleus73.52140.94537No
